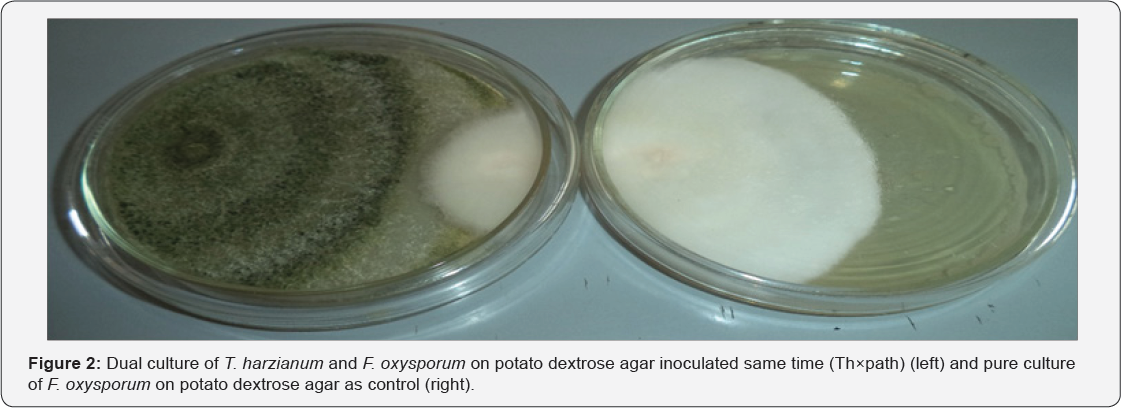
Click here to view Large Figure 2

Evaluation of Antagonistic Effect of Trichoderma Harzianum against Fusarium oxysporum causal Agent of White Yam (Dioscorearotundata poir) Tuber Rot
Nwankiti AO1 and Gwa VI1,2*
1Department of Crop and Environmental Protection, Federal University of Agriculture, Nigeria
2Department of Crop Production and Protection, Federal University, Nigeria
Submission: February 01, 2018; Published: February 22, 2018
*Corresponding author: Gwa VI, Department of Crop Production and Protection, Faculty of Agriculture and Agricultural Technology, Federal University, Nigeria, Tel: +2348039357109; Email: igwa@fudutsinma.edu.ng
How to cite this article: Nwankiti A, Gwa V. Evaluation of Antagonistic Effect of Trichoderma Harzianum against Fusarium oxysporum causal Agent of White Yam (Dioscorearotundata poir) Tuber Rot. Trends Tech Sci Res. 2018; 1(1): 555554. DOI: 10.19080/TTSR.2018.01.555554
Abstract
Studies were carried out on biological control using dual culture method to assess the potential of Trichoderma harzianum against Fusarium oxysporum, the causal agent of tuber dry rot disease of white yam in vitro. The rot-causing fungal organism was isolated from rotted yam tubers collected from different storage barns in Zaki-Biam, Benue State of Nigeria. The biological agent (T harzianum) was introduced at three different times (same time with the pathogen, 2 days before the inoculation of the pathogen and 2days after the inoculation of the pathogen). The experiment was conducted in the Advanced Plant Pathology Laboratory, Federal University of Agriculture, Makurdi, Nigeria. The plates were incubated for 192 hours and measurements of mycelial radial growths were done at 24 hours intervals beginning from 72hour. The result of the in vitro interactions showed that the highest percentage growth inhibition of mycelia of the pathogen (77.99%) was recorded when T. harzianum was introduced two days before the inoculation of F. oxysporum, followed by introduction of T. harzianum same time with F. oxysporum (45.69%) and the least percentage growth inhibition (13.72%) was recorded when the antagonist was introduced two days after inoculation of the pathogen. In all the treatments, T. harzianum was able to significantly (P<0.05) inhibits the growth of F. oxysporum throughout the period of incubation. T. harzianum was observed to be effective in reducing the mycelial growth of F. oxysporum in culture in all the treatments and therefore showed the potential for biological control of the pathogen. Minimum inhibition concentration recorded showed that the effectiveness levels of T. harzianum were slightly effective to effective across treatments. It is therefore concluded that the antagonistic potentials of T. harzianum could be used as a good biological control agent of yam tuber rot caused by F. oxysporum.
Keywords: Rot; In vitro; T. harzianum; Antagonistic; F. oxysporum; Yam; Inhibition
Abbreviations: PDA: Potato Dextrose Agar; PGI: Percent Growth Inhibition; MIC: Minimum Inhibition Concentration; CRD: Completely Randomized Design; LSD: Least Significance Difference
Introduction
Yam (Discorea) is a major staple food crop in West Africa, where it provides food for over 60 million people [1,2] estimated that the world production of yams is around 20 million tons per year. In spite of the high volume of yam production, rotting of yam in storage continue unabated. Fungal organisms commonly involved in yam rots includes: Aspergillus niger, Botryodiplodia theobromae, Fusarium solani, Fusarium oxysporum, Penicillium, Rhizopus stolonifer and Mucor [3-5]. Losses due to post-harvest rot significantly affect farmers' and traders' income, food security and seed yams stored for planting. Studies conducted by Okigbo RN [6] indicated that between 20 and 39.5% of stored tubers may be lost to rot organisms in storage. The use of synthetic chemicals such as sodium orthiophenylphenate, mancozeb and borax has been found to reduce storage rot in yam [4,7]. However, biological control is generally favoured as a method of plant disease management [8,9].This is because it is selective in action, produces no side effect and cost less. Resistance to biological control is rare and biological control agents are self- propagating and self-perpetuating [6]. The aim of this research was to study the antagonistic activities of a bio agent, T. harzianum introduced at different times in vitro to control Fusarium oxysporum, the causal agent of dry rot of yam tubers.
Materials and Methods
The study area
The experiment was conducted at the Advanced Plant Pathology Laboratory, Federal University of Agriculture, Makurdi, Nigeria.
Source of T. harzianum isolate
The biological control agent (T. harzianum) was obtained from yam Pathology Unit of University of Ibadan, Oyo State, Nigeria. Stock cultures of the isolate were maintained on slants of acidified Potato Dextrose Agar (PDA) in McCartney bottles for subsequent studies.
Collection of disease yam tubers
Rotten yam tubers of white yam varieties (Dioscorea rotundata) showing various diseased symptoms of dry rots were obtained from yam farmers from various storage barns in Zaki- Biam, Ukum local government area of Benue State, Nigeria which lies between longitudes 9° 25' and 9° 28'E, and latitude 7° 32' and 7° 35'N respectively The rotten yam tubers were packaged in sterile polyethylene bags. The tubers were protected using wire mesh to prevent rodent attack [10]. Potato Dextrose Agar (PDA) was the medium used. Test fungus for this study was F. oxysporum.
Isolation and identification of F. oxysporum
F. oxysporum was isolated from naturally infected yam tubers. Small sizes of approximately 2x2mm were cut out with sterile scalpel from yam tubers infected with rot at inter-phase between the healthy and rotted portions of the tubers. The cut tissues were soaked in 5% sodium hypochlorite for 2minutes for surface sterilization and then rinsed in four successive changes of sterile distilled water as reported by Ritchie B [11]. The infected tissues were later picked onto sterile filter paper using a sterile forceps and then wrapped with filter paper for 2-3minutes. The dried infected tissues were placed on several prepared sterile plates of acidified Potato Dextrose Agar (PDA) and the plates were incu-bated at ambient room temperature (30±5 °C) for 192 hours. The different fungi that grew from infected tissues were sub-cultured on separate sterile acidified PDA plates and incubated to obtain pure cultures of pathogens. Macroscopic and microscopic examination and morphological characteristics and identification were made and compared with already established authorities [12,13].
Antagonistic potential of T. harzianum against F. oxysporum in vitro
The assay for antagonism was performed on Potato Dextrose Agar (PDA) on Petri dishes by the dual culture method [14]. The mycelial plugs (5mm diameter) of 5 day old fungal antagonist and pathogen were placed on the same dish 6cm from each other. Isolate of test fungal antagonist was plated same time with pathogen, two days before the inoculation of the pathogen and two days after the inoculation of the pathogen. Paired cultures were incubated at room temperature (30±5 °C) for 192hours. Dishes inoculated only with test pathogens served as controls. Treatments comprised times of introduction of antagonist which were replicated three times for each treatment and arranged in completely randomized design [15].
Measurement of radial mycelial growth
Measurement of mycelia radial growths of the pathogen in dual culture and in control plates were done at 24 hour interval beginning from the 72nd hour up to the 192nd hour of incubation at ambient room temperature (30 ± 5 °C). Percent Growth Inhibition (PGI) of pathogen was also calculated as described by Korsten L [16].

PGI = Percent Growth Inhibition
R = the distance (measured in mm) from the point of inoculation to the colony margin in control plate,
R1 = the distance of fungal growth from the point of inoculation to the colony margin in treated plate in the direction of the antagonist.
The percent growth inhibition was calculated and values were used in selecting the Minimum Inhibition Concentration (MIC) that will be effective in controlling F. oxysporum. Antagonist was also rated for inhibitory effects using a scale by Sangoyomi T [17]:
≤ 0% inhibition (not effective),
>0-20% inhibition (slightly effective)
>20-50% inhibition (moderately effective),
>50-<100% inhibition (effective)
100% inhibition (highly effective)
Experimental design and data analysis
The experimental design was Completely Randomized Design (CRD) with three replicates as described by Gomez KA [15]. Test of variance was calculated using Analysis of variance (ANOVA) and statistical F-tests were evaluated at P≤0.05. Differences among treatment means for each measured parameter were further separated using fishers Least Significance Difference (LSD) to determine levels of significance according to Cochran GW [18].
Results
Isolation and identification of F. oxysporum
Fungal organisms including F. oxysporum were isolated and identified as one of the rot-causing pathogens of white yam tubers in storage in the study area. F. oxysporum was used as test pathogen in this study. Colony of F. oxysporum on PDA was moderately fast growing and produced a varying amount of aerial mycelium, initially white, and changing to peach, salmon, wine grey to purple or violet colour (Figure 1). Mycelia became thickly matted and sometimes wrinkled in older colonies. Spore masses were creamy white in colour. Macroconidia borne on short, branched conidiophores were generally abundant, hyaline, single-celled and variable, oval to kidney shaped. Macroconidia were hyaline, thin walled, only slightly curved and pointed at both ends, 3-7 septate, with a somewhat hooked apex and a foot-shaped basal cell (Figure 1).

Antagonistic potential of T. harzianum against F. oxysporum in vitro
The antagonistic potential of T. harzianum against F. Oxysporum show increased in inhibition with days of incubation in the dual culture method. The control plates that were not inoculated with T. harzianum grew much faster when compared with F. oxysporum in the dual culture plates. The dual culture plates showed initial rapid growth of F. oxysporum which terminated at the point of contact with T. harzianum (Figure 2 & 3). When T. harzianum was introduced 2 days before inoculation of the pathogen, the antagonist overgrew the pathogen and completely colonized it (Figure 4). The interaction between T. harzianum and F. oxysporum produced spores from both the antagonist and the pathogens at the point of contact when they were introduced same time. However, spores of F. oxysporum were not seen when the antagonist was introduced 2 days before inoculation of the pathogen. Chlamadosphore were observed when the antagonist was introduced two days after the inoculation of the pathogens (Figure 5).

Table 1 show that, T. harzianum assessed in this study was able to reduced mycelia growth of F. oxysporum when grown in dual culture irrespective of the time of introduction of the antagonist. The results of dual culture indicated that T. harzianum significantly (P≤0.05) inhibited the growth of F. oxysporum at varying degrees across duration of incubation (Table 1). The findings revealed that T. harzianum introduced 2days before inoculation of F. oxysporum has the highest mean percentage growth inhibition (77.99%), followed by the introduction of T. harzianum same time with the pathogen (45.69%) and the least mean percentage growth inhibition (13.72%) was recorded when the antagonist was introduced 2 days after inoculation of the pathogen (Table 1).
Means on the same column with the same superscript are not statistically significant (P≤0.05). Means on the same row (for Mean) with the same superscript are not statistically significant (P≤0.05) by time of introduction of T. harzianum. Thxpath = T.harzianum introduced same time with pathogen; Th2 dbipath = T.harzianum introduced 2 days before inoculation of pathogen; Th2daipath = T. harzianum introduced 2 days after inoculation of pathogen.
Radial mycelial growth and determination of inhibition
Figure 6 shows the radial mycelial growth of T. harzianum and F. oxysporum in dual culture and F. oxysporum in control plates for each of the treatments from 72 hours to 196 hours of incubation. The result revealed that growth of the pathogen was more rapid in the control plates than in the dual culture plates in all the treatments. It was also found that T. harzianum grew much faster than F. Oxysporum in all the treatments in dual culture there by inhibiting the growth of the fungus.
Minimum inhibition concentration recorded showed that the effectiveness levels of T. harzianum were slightly effective (introduction of T. harzianum 2days after inoculation of pathogen) to effective (introduction of T. harzianum 2 days before inoculation of pathogen) and was found to be significantly different (P≤0.05) across treatments (Table 2).


Thxpath = T.harzianum introduced same time with pathogen; Th2dbipath = T.harzianum introduced 2 days before inoculation of pathogen; Th2daipath = T. harzianum introduced 2 days after inoculation of pathogen; MIC = Minimum Inhibition Concentration (%); ≤0% inhibition (not effective); >0-20% inhibition (slightly effective); >20-50% inhibition (moderately effective); >50-x003C;100% inhibition (effective); 100% inhibition (highly effective).
Discussion
Fungal pathogenic organisms are the major cause of yam losses in storage in major yam producing areas of Nigeria. The rot-causing pathogens reduce output and productivity of yam annually. This has always placed the demand for yam tubers above its supply [19]. This result is similar to the work of [3,20,21] who had earlier on identified this organism in rotted yam tubers at different parts of Nigeria.
T. harzianum assessed in this work was able to reduced mycelial growth of F. oxysporum when grown in dual culture irrespective of the time of introduction of the antagonist. The inoculation of the test antagonists two days before the pathogen was done because there are no bio control agents that have enough competitive ability to displace an already established pathogen. The time lapse allows adequate increase in cell concentration and subsequent colonization by antagonist before the arrival of the pathogen [22]. The results of the dual culture showed that T. harzianum inhibited the growth of the target organisms through its ability to grow much faster than the pathogenic fungi thus competing efficiently for space and nutrients. Starvation was the most common cause of death for F. oxysporum, so that competition for limiting nutrients resulted in biological control of the test pathogen. This finding is similar to the work of [9,23]. Antagonists may also affect growth of pathogen either through antibiosis or mycoparasitism [24]. It was observed microscopically that the interaction region between F. oxysporum with T. harzianum showed mycelia of T. harzianum grew on the surface of the pathogen and later penetrated the cell walls directly without formation of appresorium structures. It also prevented the formation of both micro and macro conidia of the test fungus when the antagonist was introduced 2 days before inoculation of the pathogen. The pathogen mycelial then disintegrated suggesting enzyme action. This result agreed with the work done by Mokhtar H et al. [2 5] who reported the inhibition of the growth and spore formation of F. acuminatum by 66.66% using T. harzianum in vitro. Research conducted by Lorito M et al. [26] demonstrated possible role of chitinolytic and/or glucanases enzymes in bio-control by Trichoderma. They showed that the enzymes function by breaking down the polysaccharides, chitin, and glucans that are responsible for the rigidity of fungal cell walls, thereby destroying cell wall integrity limiting the growth of the pathogen.
Microscopic observation also showed that the antagonist, T. harzianum prevented the formation of spores of the test pathogen. It was observed in the study that a clear zone of interaction was formed in all T. harzianum and F. oxysporum interactions except in the interaction between T.harzianum and F. oxysporum; where T. harzianum was introduced 2 days before inoculation of F. Oxysporum where T. harzianum over grew the pathogen in the dual culture plates. The zones of inhibition produced might be due to the production of antifungal metabolites by the test antagonist as reported by Adejumo TO et al. [27].
Studies conducted by Ekefan EJ et al. [28] showed that T. harzianum isolates suppressed the growth of Colletotrichumcapsici eventually overgrowing it within seven days. Report by Ekefan EJ et al. [29] demonstrated that the Trichoderma isolates have a strong antagonism against wilt diseases caused by Fusarium sp, invitro, on potato dextrose agar medium, when growth was decreased by 88%, 86% and 80% for Trichoderma harzianum, T. hamatum and T. viride respectively. According to [30] the antagonism in vitro of Trichoderma harzianum against Fusarium oxysporium showed an inhibition on the pathogenic fungus growth with a ratio more than 65%, moreover the volatile metabolism substances of the antagonism reduced the pathogenic fungus growth by 63% compared with controls.
The inoculation of the test antagonists two days before the pathogen was done because there are no bio control agents that have enough competitive ability to displace an already established pathogen. The time lapse allows adequate increase in cell concentration and subsequent colonization by antagonist before the arrival of the pathogen [22].
Minimum Inhibition Concentration (MIC) showed that the introduction of T. harzianum 2 days before the inoculation of F. oxysporum was more effective in controlling the pathogen compared with the introduction of the antagonist same time with the pathogen as well as the introduction of the antagonist 2 days after inoculation of the fungus [31,32]. Introduction of T. harzianum 2 days before inoculation of F. oxysporum was therefore considered more effective in controlling the pathogenic fungus in vitro [33].
Conclusion
The study found out the antagonistic potentials of T. harzianum as good biological control agent of yam tuber rot caused by F. oxysporum. The study also revealed that the best time for the introduction of bio-agent is before the arrival of the pathogen. This is because the introduction of the antagonist 2days before inoculation of F. Oxysporum in vitro gave the highest inhibition of the mycelial growth of the pathogen.
References
- Nweke FI, Ugwu BO, Asadu CLA, Ay P (1991) Production costs in yam- based cropping Systems of South-Eastern Nigeria. Resource and Crop Management Programme (RCMP) Research monograph no. 6 IITA Ibadan, Nigeria p. 29.
- Food Agricultural Organization (2000) Food Research Sheet.
- Okoro O, Nwankiti AO (2004) Post-harvest Microbial Rot of Yam in Nigeria. Pathologia p. 35-40.
- Aidoo KA (2007) Identification of yam tuber rots fungi from storage systems at the Kumasi Central market. A dissertation submitted to Faculty of Agriculture, K.N.U.S.T
- Okigbo NR, Enweremadu CE, Agu CK, Irondi RC, Okeke BC, et al. (2015) Control of white yam (Dioscorea rotundata) rot pathogen using peel extract of water yam (Dioscorea alata). Advances in Applied Science Research 6(10): 7-13.
- Okigbo RN, Ikediugwu FEO (2000) Studies on biological control of post-harvest rot of yams (Dioseorea spp) with Trichoderma viride. J Phytopathol 148(6): 351-355.
- Okigbo RN (2005) Biological Control of Postharvest Fungal Rot of Yam (Dioscorea spp.) with Bacillus subtilis. Mycopathologia 159(2): 307314.
- Amin F, Razdan VK, Mohiddin FA, Bhat KA, Saba Banday (2010) Potential of Trichoderma Species as Biocontrol Agents of Soil Borne Fungal Propagules. J Phytol 2(10): 38-41.
- Siameto EN, Okoth S, Amugune NO, Chege NC (2011) Molecular Characterization and identification of biocontrol isolates of Trichoderma harzianum from Embu District, Kenya. Tropical and Subtropical Agroecosystem 13: 81-90.
- Eze CS (1984) Studies on storage rot of cocoyam (Colocasia esculenta (L.) Schott) at Nsukka. MSc Dissertation, Dept of Botany, Univ of Nigeria, Nsukka. p. 73.
- Ritchie B (1991) Practical Techniques in Plant Pathology CAB. Wallingford, UK.
- Agrios G (2004) Plant pathology (5th edn). Elsevier, London, UK.
- Lester BW, Knight TE, Tesoriero L, Phan HT (2008) Diagnostic manual for plant diseases in Vietnam. ACIAR Monograph ACIAR: Canberra, Australia, 129: 210.
- Evans HC, Hoimes KA, Reid AP (2003) Phylogeny of the Frosty Pod rot pathogen of cocoa. Plant Pathology 52(4): 476-485.
- Gomez KA, Gomez AA (1984) Statistical procedures for Agricultural Research (2nd edn). John Wiley and sons, pp. 680.
- Korsten L, De Jager ES (1995) Mode of action of Bacillus subtilis for control of avocado post harvest pathogens. S Afr Avocado Growers Assoc. 18: 124-130.
- Sangoyomi T (2004) Post-harvest Fungal Deterioration of yam (Dioscorea rotundata. Poir) and its Control. Ph.D. Thesis. University of Ibadan, Nigeria, pp. 179.
- Cochran GW, Cox GM (1992) Experimental Designs (2nd edn). John willey and Sons Inc, pp: 611.
- Food and Agricultural Organization (2013) Food and Agricultural Organisation of the United Nations, Rome, Italy.
- Ogaraku AO, Usman HO (2008) Storage Rot of Some Yams (Dioscorea Spp) in Keffi and Environs, Nasarawa State, Nigeria. J PAT 4(2): 22-27.
- Ogunleye, AO, Ayansola OT (2014) Studies of Some Isolated Rot- Causing Mycoflora of Yams Dioscorea Spp.). Amer J Microb Biot 1(1): pp. 9-20.
- Adebola MO, Amadi JE (2010) Screening three Aspergillus spp for antagonistic activities against the cocoa black pod organism (Phytophthora palmivora). Agric Bio JN America 1(3): 362-365.
- Abdollahzadeh J, Goltapeh EM, Rouhani H (2003) Evaluation of antagonistic effect of Trichoderma species in biological control of causal agents of crown and root rot of sunflower (Sclerotinia minor) In vitro. Agricultural Sciences Tabriz 13(2): 13-23.
- Saba Banday Dar GH, Ghani MY, Sagar V, Nasreen F (2008) In vitro interaction of bio agents against Dematophora necatrix and Pythium ultimum causing apple root rot in Jammu and Kashmir Journal 10: 341350.
- Mokhtar H, Aid D (2013) Contribution in isolation and identification of some pathogenic fungi from wheat seeds, and evaluation of antagonistic capability of Trichderma harzianum against those isolated fungi in vitro. Agric Boil J N Am 4(2): 145-154.
- Lorito M, Woo SL, Garcia Fernandez I, Colucci G, Harman GE, et al. (1998) Genes from mycoparasitic fungi as a source for improving plant resistance to fungal pathogens. Proc Natl Acad Sci USA 95(14): 78607865.
- Adejumo TO, Ikotun T, Florin DA (1999) Biological control of Protomycopsis phaseoli, the causal agent of leaf smut of Cowpea. J Phytopathology 147(6): 371-375.
- Ekefan EJ, Jama A, Gowen SR (2009) Potential of Trichoderma harzianum isolates in bio control of Colletotrichum capsici causing anthracnose of pepper (Capsicum spp.) in Nigeria. J Appl Bios 20: 1138-1145.
- Azza AT, Allam DA (2004) Improving cumin production under soil infestation with Fusarium Pathogen 1-screening of biocontrol agents. Ass. Univ. Bull Environ Res 2: 35-45.
- Hibar K, Mejda D, Haifa K, Mohamed E (2005) Effect inhibiteur in vitro et in vivo du Trichoderma harzianum sur Fusarium oxysporium f.sp. radicis-lycopersici. Biotechnol Agron Soc Environ 9(5): 163-171.
- Gwa VI, Nwankiti AO (2017) In Vitro Antagonistic Potential of Trichoderma harzianum for Biological Control of Fusarium moniliforme Isolated from Dioscorea rotundata Tubers. Virol-mycol 6(2): 166.
- Gwa VI, Ekefan EJ (2017) Fungal Organisms Isolated from Rotted White Yam (Dioscorea rotundata) Tubers and Antagonistic Potential of Trichoderma harzianum against Colletotrichum Species. Agri Res & Tech: Open Access J 10(3): 555787.
- Gwa VI, Ekefan EJ (2017) Potential for Biological Control of Postharvest Fungal Rot of White Yam (Dioscorea Rotundata Poir.) Tubers during Storage with Trichoderma Harzianum. J Plant Physiol Pathol 5: 4.






























